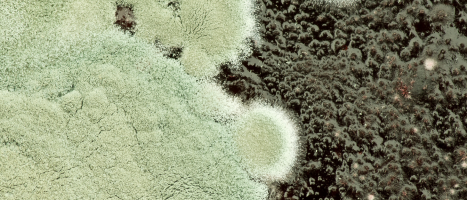

Sveikata
 Gegužės 28-oji – Tarptautinė moterų sveikatos gerinimo diena: su kokiais negalavimais susiduria moterys?
Gegužės 28-oji – Tarptautinė moterų sveikatos gerinimo diena: su kokiais negalavimais susiduria moterys?
 Kai pavasaris ne džiugina, o vargina: kaip palengvinti sezoninės alergijos simptomus?
Kai pavasaris ne džiugina, o vargina: kaip palengvinti sezoninės alergijos simptomus?
 Alergijos simptomai: kaip juos palengvinti ir kada kreiptis į specialistus? Atsako mūsų partneriai „Affidea Lietuva“
Alergijos simptomai: kaip juos palengvinti ir kada kreiptis į specialistus? Atsako mūsų partneriai „Affidea Lietuva“